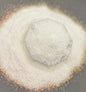

1
/
of
1
White Horse {Fine}
White Horse {Fine}
Regular price
$10.50 USD
Regular price
Sale price
$10.50 USD
Unit price
/
per
Shipping calculated at checkout.
Couldn't load pickup availability
- 2oz Glitter by weight
- Color: High Flash Iridescent White / Hypershift
- Cut Size: Fine 1/64
- Type: High Flash Iridescent
*Please be aware that colors may shift and look differently depending on computer screens, lighting etc.
Share